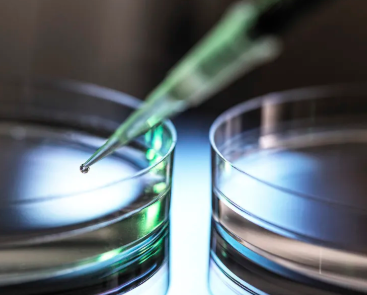
中国供卵试管婴儿医院有哪些,试管备孕需要做些什么准备工作？*活中要注意哪些问题？

作者:admin
日期:2025-03-15
首先,要做好体检
怀孕前做好体检也是非常必要的。如果怀孕后突然发现身体感染,很难处理。毕竟不能随意用药,很可能会影响胎儿的长发育,出现胎儿畸形等问题。而且,如果绝对需要用药,只能选择流产,所以提前做好体检是非常必要的,括口腔检查。主要是看有没有智齿,如果有智齿,应该在怀孕前拔掉,智齿对胎儿也会有很大的影响。
二是要注意日常饮
在日常饮食中应该更加注意,事实上,即使是普通人,注意饮食是非常必要的,饮食与自己的健康密切相关,更不用说准备怀孕,更需要通过饮食调整自己的健康,使自己更容易怀孕。试管备孕需要做什么准备??比如饮食要清淡,不要吃油腻的食物,尽量减少外出就餐的机会,多吃富含叶酸和蛋白质的食物。叶酸对胎儿的早期发育有很大的帮助,而蛋白质可以更好地帮助提高和卵子的质量。可以自己搜索一些健康食谱,保证一日三餐的合理搭配,营养充足。
第三,要注意适当的运动
在准备怀孕时,需要自己的身体调整到最佳状态,试管备孕需要做什么准备??你可以通过锻炼来调整身体状况,事实上,现在有很多人不喜欢锻炼,但为了有一个更好的状态来迎接新的活,有必要锻炼,不是说每天有很长的锻炼时间,也不是说有一些更累的锻炼,可以选择他们更容易坚持锻炼,如慢跑等,可以调动身体功能。
全国有哪些医院供卵医院,2026廊坊月子中心排名整理,广阳各家收费标准有所差别
国内供卵的流程,2026第二代试管婴儿全部费用明细目表一览
国内哪个医院捐卵,2026年三代试管***价格多少和你想象的不一样
国内代怀孕官网,2026第三代试管婴儿包生男孩费用需要多少?
国内哪里能做供卵,2026武汉试管婴儿医院排名榜名单正规机构价格多少很清楚
国内供卵医院在哪,2026马来西亚和泰国哪个做试管婴儿好
国内供卵排队,2026年鹤壁试管婴儿助孕医院最好排名一览
国内最可靠代怀,2026冷冻精子挂什么科、要啥手续全囊括,想留后路必看
全国供卵医院排名榜,漯河试管婴儿医院排名2026造娃价目表、*率参考
国内试管代怀产子机构代生,商丘助孕试管医院名单一览,2026试管收费价目表